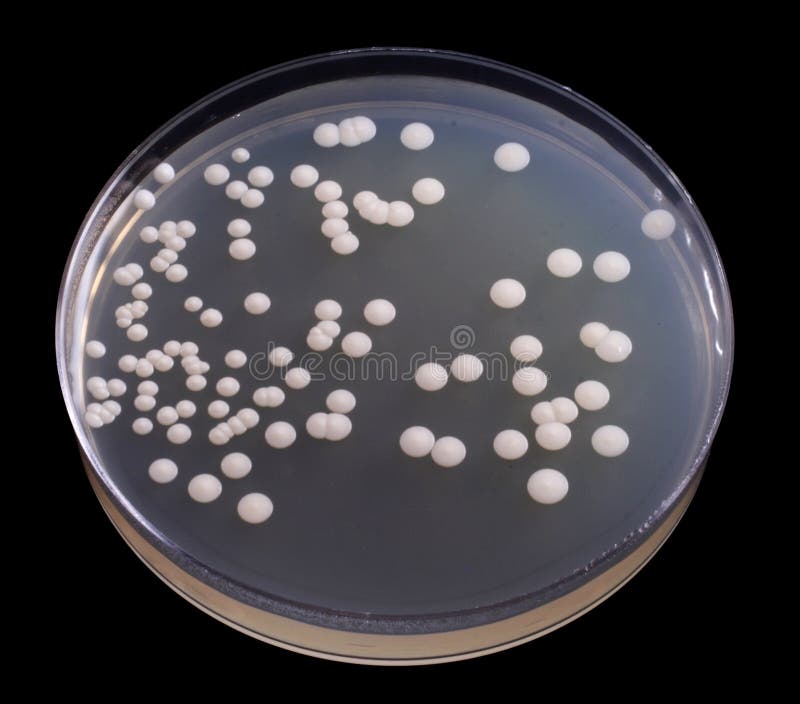
Bacteria royalty free stock photo

Royalty-Free Stock Photo
Chemical Laboratory. Cartoon Background. Vector Illustration EPS 10.
4
17
- ?
Size MAX
5000x3367px •
16.7" x 11.2" • @300dpi •
2.6MB • jpg
Author credit line
Image keywords
Related searches
Designers Also Selected These Stock Illustrations

More similar stock illustrations




















More stock photos from Visual Generation's portfolio




















